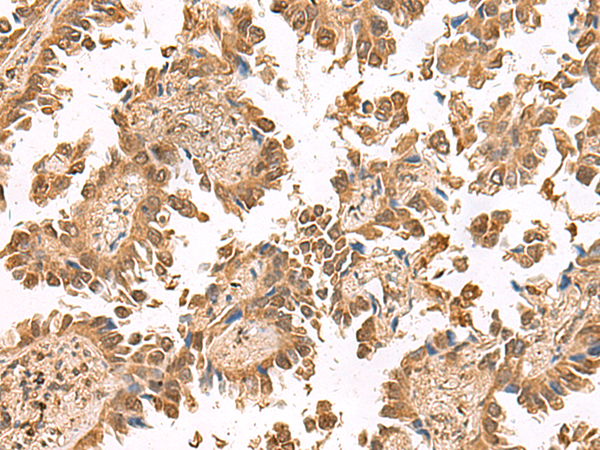

别名:PFE; PTHR; PTHR1应用:IHC
反应种属:Human, Mouse, Rat
规格:50μl/100μl
| Description |
|---|
| The protein encoded by this gene is a member of the G-protein coupled receptor family 2. This protein is a receptor for parathyroid hormone (PTH) and for parathyroid hormone-like hormone (PTHLH). The activity of this receptor is mediated by G proteins which activate adenylyl cyclase and also a phosphatidylinositol-calcium second messenger system. Defects in this receptor are known to be the cause of Jansen’s metaphyseal chondrodysplasia (JMC), chondrodysplasia Blomstrand type (BOCD), as well as enchodromatosis. Two transcript variants encoding the same protein have been found for this gene. |
| Specification | |
|---|---|
| Aliases | PFE; PTHR; PTHR1 |
| Swissprot | Q03431 |
| Host/Isotype | Rabbit IgG |
| Storage | Store at 4°C short term. Aliquot and store at -20°C long term. Avoid freeze/thaw cycles. |
| Species Reactivity | Human, Mouse, Rat |
| Immunogen | Fusion protein of human PTH1R |
| Formulation | pH7.4 PBS, 0.05% NaN3, 40% Glycerol |
| Application | |
|---|---|
| IHC | 1/50-1/300 |
| ELISA | 1/5000-1/10000 |
![]() |
The image is immunohistochemistry of paraffin-embedded Human liver cancer tissue using P03098(PTH1R Antibody) at dilution 1/55. (Original magnification: ×200) |
![]() |
The image is immunohistochemistry of paraffin-embedded Human lung cancer tissue using P03098(PTH1R Antibody) at dilution 1/55. (Original magnification: ×200) |
本公司的所有产品仅用于科学研究或者工业应用等非医疗目的,不可用于人类或动物的临床诊断或治疗,非药用,非食用。
暂无评论
本公司的所有产品仅用于科学研究或者工业应用等非医疗目的,不可用于人类或动物的临床诊断或治疗,非药用,非食用。
中文

发表回复